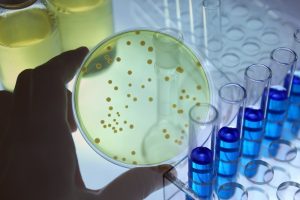
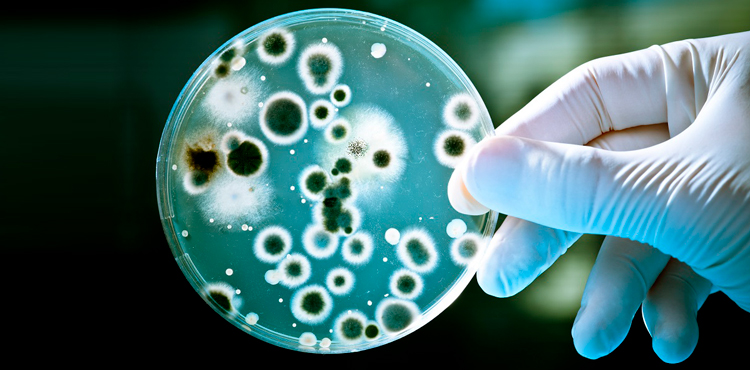

¿Qué es una incubadora de CO2?
En una incubadora de CO2, también llamadas incubadoras de gasificación, se garantiza el desarrollo de cultivos celulares y de tejidos creando una atmósfera natural. Este cultivo de organismos vivos in vitro es una de las aplicaciones principales de las incubadoras de CO2.
Este proceso puede darse durante varias semanas.
El crecimiento y la seguridad de las pruebas son siempre la máxima prioridad.
Para garantizar esto, la temperatura, la humedad y el contenido de CO2 deben cumplir los requisitos de los cultivos celulares de la mejor manera posible.
Estructura y función de una incubadora de CO2

Una incubadora de CO2 cuenta con un interior completamente aislado del entorno para evitar la contaminación de la atmósfera dentro del equipo.
Además de una puerta convencional, la mayoría de las incubadoras de CO2 cuentan con una puerta vidriada para que los técnicos puedan observar en forma directa los ensayos durante la fase de crecimiento.
La puerta de vidrio ofrece protección adicional contra la contaminación.
El interior está realizado, en general, de materiales de fácil limpieza como el acero inoxidable.
Adicionalmente, se diseñan con ángulos redondeados que facilitan su limpieza y desinfección.
Una sola bacteria o virus que ingrese a las estufas de cultivo y se desarrolle en el medio de cultivo de las células bajo ensayo, puede contaminar la muestra y se habrán perdido semanas de trabajo..
Los gases que ingresan a la estufa lo hacen a través de un filtro HEPA de alta eficiencia. Además, deben distribuirse de forma uniforme por todo el interior, ya que los ensayos con células suelen colocarse a distintas alturas.
El desafío consiste en conseguir una atmósfera homogénea en el interior, de modo de garantizar que todas los ensayos tengan un abastecimiento uniforme de CO2 con condiciones de temperatura y humedad constantes.
Son parámetros decisivos para el cultivo de células:
- Nivel de CO2
- Temperatura
- Humedad del aire
Áreas de aplicación de Incubadoras de CO2
Las incubadoras de CO2 se usan principalmente en investigación médica y en la industria farmacéutica. En otras áreas en las que se necesitan cultivos de células en condiciones absolutamente estériles también se utilizan incubadoras de CO2 para garantizar condiciones de cultivo estériles.
Guidelines sobre el manejo de incubadoras de CO2
Validación
Varias directivas regulan el manejo de incubadoras de CO2. En la industria farmacéutica, las exigencias de las buenas prácticas de laboratorio (BPL) y las Buenas prácticas de Manufactura (GMP) descriptas en el 21 CFR parte 11 definen y regulan la manipulación de los dispositivos de medición, que deben calibrarse y comprobarse en intervalos definidos.
Un registrador de datos debe registrar todos los parámetros de los ensayos y transferirlos al software y al soporte de memoria en el que se va a procesar y archivar.
¿Cuándo está preparada una incubadora de CO2 para su uso?
En general, las incubadoras de CO2 pasan por tres pasos en su calificación:
Calificación de la instalación (Installation Qualification, IQ): en el primer paso, se prueba la función de todos los componentes de la incubadora de CO2.
Calificación operativa (Operational Qualifications, OQ): en este paso, se prueba el rendimiento de la incubadora de CO2 con la cámara vacía, para comprobar si es posible mantener un rango de temperatura determinado y si el registrador de datos está calibrado correctamente.
Calificación de performance (Performance Qualifications, PQ): a continuación, se determina si la incubadora también mantiene los niveles de temperatura cuando tiene carga en su interior.
Calibración
Como se indicó anteriormente, existen varias directivas que regulan el buen uso de las incubadoras de CO2, en ellas se exige la verificación periódica de las mediciones y niveles de temperatura, humedad y CO2, esto garantiza que las condiciones de los ensayos son las precisas para el proceso que se está ejecutando.
¿Por qué es importante la validación y la calibración?
- Garantizar las condiciones de los ensayos realizados
- Brindar seguridad al personal que opera la estufa.
AKRIMET dispone de equipamiento y personal calificado para la ejecución de calibraciones y calificaciones de estufas de CO2. Lo invitamos a consultarnos por los ensayos.